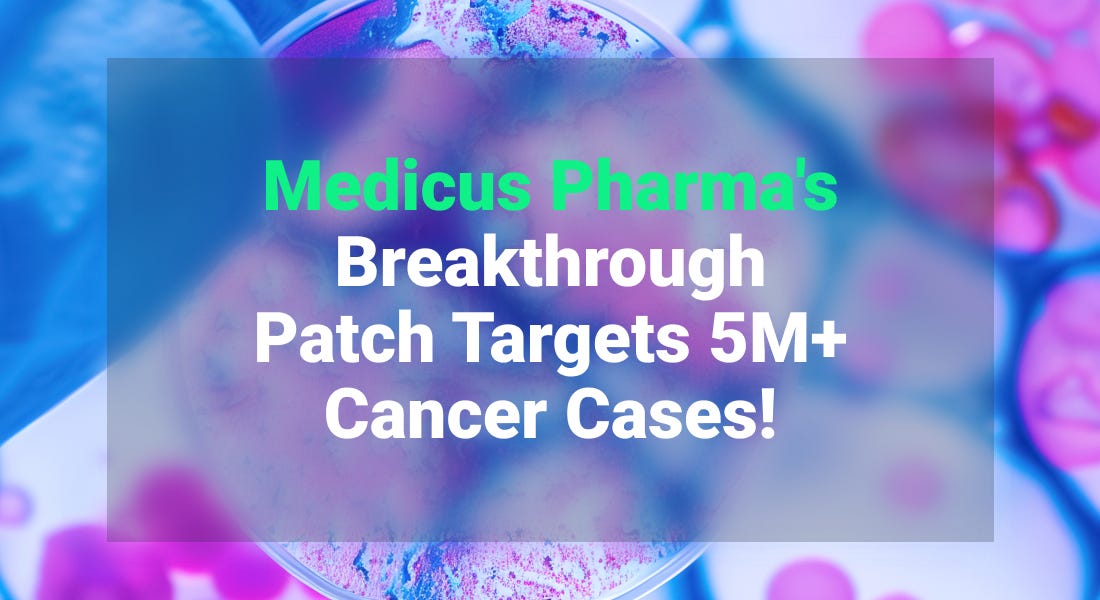

🔌 Fast Charging Breakthrough, Klarna’s Comeback & Electrifying Construction 🦺
In under 5 minutes, let us introduce you to investing opportunities found in recent market analysis. Grow your portfolio with knowledge.
Market Summary
Equities lower.
Bond yields lower.
Oil up. Gold up.
Bitcoin up.
Investing Unlocks: How to Capitalize on the Hot Topics From The Last 7 Days
We analyze recent trends and opportunities, offering strategic insights that help you manage risks and identify growth opportunities for your portfolio.
BYD Ultra-Fast EV Charger
BYD has introduced a new battery and charging system capable of delivering 470 kilometers (292 miles) of range in just five minutes. The breakthrough, tested on the Han L model, significantly reduces charging time, making EVs more competitive with traditional gasoline vehicles. This innovation strengthens BYD’s position in the global EV market, where it is emerging as a key rival to Tesla. The system will be integrated into future models, potentially accelerating EV adoption among drivers concerned about long charging stops.
Why investors should care:
Game-Changing Technology: BYD’s ultra-fast charging system reduces one of the biggest barriers to EV adoption, making electric cars more competitive with gasoline vehicles.
Stronger Market Position: This innovation reinforces BYD’s challenge to Tesla, solidifying its leadership in the EV market and enhancing its global expansion strategy.
Increased EV Adoption Potential: Faster charging could drive higher consumer demand, benefiting BYD’s sales growth and long-term revenue prospects.
Competitive Differentiation: BYD’s new technology sets it apart from other automakers, strengthening its brand and boosting investor confidence.
Tesla tumbles again as investors bail on Elon Musk's suddenly struggling electric vehicle company.
Klarna IPO
Klarna, the Swedish fintech company renowned for its buy-now-pay-later (BNPL) services, has publicly filed for an initial public offering (IPO) in the United States. The company plans to list its shares on the New York Stock Exchange under the ticker symbol KLAR. The company's valuation soared to $45.6 billion in 2021 but declined to $6.7 billion in 2022. The current IPO aims to restore some of that lost valuation, reflecting renewed investor confidence. At IPO, Klarna is targeting a valuation in the $15-20 billion range.
Why investors should care:
Strong Revenue Growth: Klarna’s revenue surged 24% year-over-year to $2.81 billion in 2024, demonstrating its ability to scale despite economic headwinds.
Return to Profitability: After years of losses, Klarna turned a net profit of $21 million, signaling improved cost control and a sustainable business model.
Expanding Beyond BNPL: Klarna is evolving beyond BNPL into AI-driven shopping, payments, and financial services, diversifying its revenue streams.
Massive Market Opportunity: The global digital payments and e-commerce financing market is growing, giving Klarna room for expansion, particularly in the U.S.
Attractive IPO Valuation: At $15-20 billion, Klarna is debuting at a discount compared to its $46 billion peak, offering potential upside for long-term investors.
PRESENTED BY MEDICUS PHARMA LTD.
Medicus Pharma Ltd (NASDAQ: MDCX) offers a rare chance to invest in breakthrough cancer technology in a $15B market. They are advancing a patent-protected skin cancer patch through Phase 2 trials with promising clinical progress! This skin cancer patch offers a non-invasive treatment with strong growth potential, targeting 5M+ skin cancer cases yearly in the United States.
Future-Focused Innovation
The construction industry is moving away from fossil fuels toward electric machinery due to environmental concerns, stricter pollution regulations, and demand for quieter operations. Electric construction equipment remains rare on most global worksites, but things are beginning to change.
China is the largest market, with battery-powered equipment accounting for 2% of sales, valued at over $1 billion annually. The EU and US lag behind, with electric construction machinery making up 1.5% and 1% of the total market share, respectively.
Major manufacturers like Volvo and Takeuchi are producing large electric excavators, while cities such as Oslo are leading the shift to emissions-free construction. Other cities, including London, are exploring similar initiatives through pilot programs and policy incentives.
Stricter noise and pollution regulations in urban areas could accelerate adoption, as electric construction machinery is up to 75% quieter than diesel-powered models. Reduced noise pollution could help minimize public complaints, enable longer working hours, and improve conditions for both workers and city residents.
Investing Data Story
The growth of the basal cell carcinoma treatment market is strongly supported by increased investment in research. Discover the Biotech Stocks Tackling the World’s Most Common Cancer.
Earnings Performance
Wheaton Precious Metals Corp.
Wheaton Precious Metals Corp (NYSE: WPM) achieved record revenue, adjusted net earnings, and operating cash flows in 2024. The company's gross margin rose by 40% to $247 million during Q4, 2024. However, net earnings were impacted by a $109 million impairment charge returning $88 million. Wheaton's gross margin for 2024 rose by 28% to $803 million, driven by higher sales volumes and increased commodity prices.
Other Earnings Updates
Analyst Strong Buy Ratings This Week! 📈
Looking for stocks with strong analyst backing? These companies have earned top-tier "Strong Buy" ratings from analysts, signaling potential upside for investors.
Whether you’re eyeing small-to-mid cap opportunities in the U.S. and Canada or want to stick with trusted S&P 500 blue-chip picks, this list highlights stocks that experts believe could outperform.
🔍 Do your research and see if any of these fit your portfolio!
Top Reads
🏆 UBS Group AG became the latest bank to raise its price outlook for gold on increasing chances of a protracted global trade war. UBS Boosts Gold Target to $3,200 as Trade Risks Stay Elevated.
⚓ Maritime defence and oceanographic survey company, Saildrone delivers essential surveillance of maritime territories for the US Navy, Department of Homeland Security, and allies. It has teamed up with Palantir Technologies to enhance its use of artificial intelligence (AI) for security and monitoring at sea. Saildrone, Palantir partner for advanced maritime AI.
💻 Intel CEO Lip-Bu Tan was named CEO of the chipmaker last week, after Pat Gelsinger was ousted in December. Intel Leadership Change Signals New Opportunities.
🏥 Hospitals say AI is helping their nurses work more efficiently while addressing burnout and understaffing. But nursing unions argue that this poorly understood technology is overriding nurses' expertise and degrading the quality of care patients receive. As AI nurses reshape hospital care, human nurses are pushing back.

Thanks for this post, will indeed be interesting to follow the Klarna IPO.